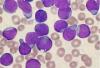
Китайские  ученые утверждают, что они  успешно лечат рак мышьяком.

отметили
74
человека
в архиве
Временное правительство Киргизии пообещало Бакиеву "народный самосуд"
 lenta.ru
lenta.ru
Временное правительство Киргизии может ужесточить свою позицию в отношении президента республики Курманбека Бакиева. Об этом сообщает "Интерфакс" со ссылкой на заявление, которое сделала глава временного правительства Роза Отунбаева. По ее словам, народ Киргизии недоволен тем, что Бакиеву ...
12 комментариев
отметили
21
человек
в архиве
Авиакатастрофы и мировые политики bbc.co.uk
За историю авиации в авиакатастрофах погибли по меньшей мере 15 политиков, состоявших в ранге главы государства. Причины многих авиакатастроф так и остались неизвестны
проблема (1)
отметили
60
человек
в архиве
Китайские ученые утверждают, что они успешно лечат рак мышьяком.
 news.israelinfo.ru
news.israelinfo.ru
Группа китайских ученых, в состав которой входит и министр здравоохранения страны Шен Жу, опубликовала в журнале Science статью о механизме терапевтического действия мышьяка при одной из разновидностей острого лейкоза (APL).
Китайские ученые, используя новейшую западную аппаратуру, выяснили...
отметили
35
человек
в архиве
Американская домохозяйка показала себя способной ученицей мужа-адвоката, выиграв судебный иск против его любовницы в размере 9 миллионов долларов
 news.israelinfo.ru
news.israelinfo.ru
60-летняя Синтия, расставшаяся с мужем пять лет назад, сумела доказать суду, что в ее разводе и причиненных им эмоциональных страданиях повинна именно «разлучница», 49-летняя Энн Лундквист, с которой ее 62-летний муж познакомился по работе.
Несмотря на то, что муж истицы, Алан Шеклфорд, пов...
проблема (7)
отметили
25
человек
в архиве
Тяжела ты, шапка Мономаха!
 s47.radikal.ru
s47.radikal.ru
Мер Волгограда Роман Гребенников. Три года у власти превратили 30-летнего политика-коммуниста в одного из самых ненавистных чиновников-демократов.
проблема (1)
отметили
58
человек
в архиве
В начальных школах Британии детям рассказывают о насилии с помощью игры Grand Theft Auto, фотографий пьяных людей, ножей, шприцов и ссорящихся родителей
 news2day.ru
news2day.ru
Полиция и городской совет Ливерпуля, а также организация Поддержка после убийства и насилия одобрили образовательный проект Get Real, в рамках которого в восьми начальных школах города проводятся занятия на тему того, чем насилие в реальной жизни отличается от вымышленного.
Детям показывают...
отметили
16
человек
в архиве
отметили
37
человек
в архиве
Михаил Саакашвили наградил погибшего президента Польши орденом "Национальный Герой Грузии"
 newsru.com
newsru.com
По решению президента Грузии Михаила Саакашвили президент Польши Лех Качиньский посмертно удостоен звания и ордена "Национальный Герой Грузии". Об этом сообщила сегодня журналистам пресс- секретарь президента Манана Манджгаладзе. Озвучивая позицию и решение Саакашвили, она сказала, что &qu...
проблема (8)
отметили
102
человека
в архиве
Экипаж разбившегося под Смоленском самолета не выполнил указаний руководителя полетов аэродрома "Смоленск"
 interfax.ru
interfax.ru
Экипаж самолета польского президента, который разбился в субботу в Смоленской области, несколько раз не выполнил указаний руководителя полетов аэродрома "Смоленск", заявил журналистам первый заместитель начальника главного штаба ВВС генерал-лейтенант Александр Алешин.
"На уда...
отметили
17
человек
в архиве
Полный список пассажиров разбившегося под Смоленском Ту-154
 rian.ru
rian.ru
Президент Лех Качиньский (Lech Kaczy?ski)
Супруга президента Мария Качиньска (Maria Kaczy?ska)
Последний президент Польской Республики в изгнании Рышард Качоровский (Ryszard Kaczorowski)
Вице-спикер Сейма Кшиштоф Путра (Krzysztof Putra)
Вице-спикер Сейма Ежи Шмайдзиньский (Jerzy...
проблема (5)
отметили
26
человек
в архиве
Важной отличительной чертой обеспеченных россиян является их "патриотизм"
 ng.ru
ng.ru
Группа состоятельных граждан, в которую входят менее 1% населения, переживает экономические невзгоды довольно спокойно. Такие выводы опубликовали вчера эксперты Российской экономической школы (РЭШ) и Ситибанка, изучавшие поведение россиян, свободные средства для инвестиций которых превышают 50 тыс. ...
проблема (1)
отметили
10
человек
в архиве
Самолет, на котром летал президент Польши, отремонтировали на "Авиакоре" в Самаре. После этого ему назначили срок службы более 25
 vesti.ru
vesti.ru
В декабре прошлого года самолёт президента Польши проходил ремонт в Самаре. Салон Ту-154 сочетал функциональность офиса, который оснащён по последнему слову техники, с комфортом пятизвёздочного отеля. Всё убранство — класса "люкс", как и полагается для первого лица государства. Ту-154 испо...
отметили
153
человека
в архиве
СМИ Польши задаются вопросом, зачем руководство село в один самолет
 rian.ru
rian.ru
«Поворотным моментом в польской истории и одной из ее величайших трагедий» назвал гибель президента Польши и множества высокопоставленных чиновников страны корреспондент газеты The Wall Street Journal Марцин Собчик (Marcin Sobczyk).
В один момент «страна лишилась всего военного командования...
отметили
18
человек
в архиве
Мышь Грызлов
 i062.radikal.ru
i062.radikal.ru
Это разворот из книги "Мышарики: Книга Мышей для больших и малышей" Андрея Усачева. К сожалению, не очень хорошо видно, но пепельница стоит на красной книжке, на корешке которой написано "В.В. Путин".
Разные интернет-источники отметились на эту тему еще зимой, а я вот сегодня...
отметили
66
человек
в архиве
Военные пенсионеры на митинге в Калининграде потребовали отставки министра обороны Анатолия Сердюкова
 regnum.ru
regnum.ru
Митинг военных пенсионеров в Калининграде с требованием отставки министра обороны Анатолия Сердюкова собрал от 600 до 2 тысяч человек. Как передает корреспондент ИА REGNUM Новости с места события, люди митинговали сегодня, 10 апреля, в центре Калининграда у памятника "Матери-родины".
...
отметили
85
человек
в архиве
Израиль оказался на шестом месте в мире по боевому ядерному потенциалу
 cursorinfo.co.il
cursorinfo.co.il
Израиль обладает боевым атомным потенциалом, сравнимым с британским, и находится на шестом месте среди ядерных держав, сообщает журнал Jane’s Defence Weekly.
Специалисты считают, что у Израиля от 100 до 300 ядерных боеголовок, которые могут быть установлены на ракеты "Йерихо-2", д...
отметили
65
человек
в архиве
Россиянки завоевали "золото" и "серебро" на чемпионате Европы по тяжелой атлетике
 itar-tass.com
itar-tass.com
Россиянка Наталья Заболотная трижды поднялась на высшую ступень пьедестала почета на проходящем в белорусской столице чемпионате Европы по тяжелой атлетике. Выступая в весовой категории до 75 кг, она сегодня была сильнейшей в рывке /129 кг/ и толчке /156 кг/, и с суммой в двоеборье в 285 кг заняла п...
отметили
42
человека
в архиве
Колорадо: заместитель шерифа использовал электрошок в отношении 30-ти школьников
 americaru.com
americaru.com
Заместитель шерифа из штата Колорадо был отправлен в неоплачиваемый отпуск, когда выяснилось, что он использовал электрошоковый пистолет в отношении 30-ти школьников во время ярмарки, организованной средней школой.
Администрация учебного заведения сообщает, что школьники сами попросили, что...
отметили
124
человека
в архиве
Польша лишилась всего военного командования ("Gazeta Wyborcza", Польша)
 inosmi.ru
inosmi.ru
На борту правительственного "Туполева" находились почти все командующие вооруженных сил Польской Республики. Как это возможно, чтобы в один момент страна лишилась всего военного командования?
Погибли глава Генерального штаба генерал Франчишек Гонгор (Franciszek G?gor), главком сух...
отметили
62
человека
в архиве
Польский премьер заплакал, когда узнал о авиакатастрофе под Смоленском
 hvylya.org
hvylya.org
Об этом сказал в эфире Радио Zet, министр иностранных дел Польше Радослав Сикорский.
проблема (6)
отметили
71
человек
в архиве
При аварии вертолета Ми-8 на Камчатке погибли десять человек - МЧС
 rian.ru
rian.ru
Спасатели обнаружили тела семи человек, оказавшихся под лавиной, накрывшей вертолет Ми-8 на Камчатке, сообщил РИА Новости руководитель пресс-службы Дальневосточного регионального центра МЧС России Сергей Викторов.
"На данным момент спасателям удалось извлечь из-под лавины семеро погибш...
отметили
35
человек
в архиве
Скорость сайта — новый важный фактор в ранжировании поиска Google habrahabr.ru
В преамбуле, опубликованной вчера новости, по поводу изменения релевантности вывода поисковых результатов, Google говорит, цитирую:
«Возможно, вы слышали, что Google просто одержим скоростью, как в наших продуктах, так и наших веб проектах. В связи с этим, сегодня мы вводим новый показатель в на...
проблема (7)
отметили
62
человека
в архиве
СМИ опубликовали список пассажиров разбившегося самолета президента Польши
 lenta.ru
lenta.ru
Польское издание Wiadomosci со ссылкой на TVN24 опубликовало предварительный неполный список пассажиров, которые должны были лететь в самолете Ту-154, потерпевшем катастрофу в Смоленской области. Уже известно, что на борту в составе официальной делегации, направлявшейся в Смоленск для участия в трау...
отметили
8
человек
в архиве
Крушение самолета с Президентом Польши
 youtube.com
youtube.com
Последнее видео с места катастрофы, которое сейчас транслируют на весь мир. ...
отметили
71
человек
в архиве
Государственные деятели, погибшие в авиакатастрофах. Справка
 rian.ru
rian.ru
Наиболее значимой в мировом масштабе политической фигурой, ставшей жертвой авиакатастрофы, стал генеральный секретарь Организации Объединенных Наций швед Даг Яльмар Агне Карл Хаммаршельд. Его самолет разбился 18 сентября 1961 года, когда генсек ООН направлялся с миротворческой миссией в Конго (ныне ...
отметили
101
человек
в архиве
Названа предварительная версия крушения самолета президента Польши
 lenta.ru
lenta.ru
Согласно предварительной версии, причиной крушения самолета Ту-154 правительственного авиаотряда Польши стала ошибка экипажа. Об этом сообщает РИА Новости со ссылкой на источник в силовых структурах. В результате авиакатастрофы погиб президент Польши Лех Качиньский, а также десятки польских политико...
проблема (1)
отметили
29
человек
в архиве
"Аль-Каида" угрожает террористическим актом во время матча сборных Англии и США на ЧМ-2010
 ukfootball.ru
ukfootball.ru
Стартовый матч сборной Англии на ЧМ-2010 в Южной Африке против сборной США стал объектом угрозы со стороны террористической группировки, связанной с "Аль-Каидой". "Приветственное послание" базирующихся в Алжире террористов было опубликовано в пятницу вечером на одном из экстремис...
отметили
148
человек
в архиве
Расследование обстоятельств гибели президента Польши поручили Путину
 lenta.ru
lenta.ru
Президент России Дмитрий Медведев создал специальную комиссию для расследования обстоятельств авиакатастрофы Ту-154 под Смоленском, сообщает РИА Новости со ссылкой на сообщение пресс-службы Кремля. Комиссию возглавил премьер-министр России Владимир Путин. Кроме того, на место происшествия по указани...
проблема (2)
отметили
46
человек
в архиве
Американцы начнут пить морскую воду
 3dnews.ru
3dnews.ru
В наше время от нехватки питьевой воды страдают 1,2 млрд человек во всем мире. С трудностями приходится сталкиваться не только жителям бедных стран, но и людям, проживающим в засушливых районах высокоразвитых государств.
Недавно жители американского города Санд-Сити (Sand City, округ Монтер...
отметили
68
человек
в архиве
Украина требует от России больше денег за пребывание Черноморского флота
 newsru.com
newsru.com
Украина поставила вопрос о повышении арендной платы для Черноморского флота России. Об этом сообщил сегодня премьер-министр Николай Азаров в телеэфире канала Интер. "Мы предложили поднять арендную плату за пребывание этой базы в Севастополе", — сказал он.
Азаров отметил, что РФ не...